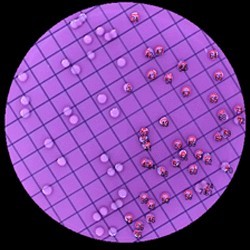
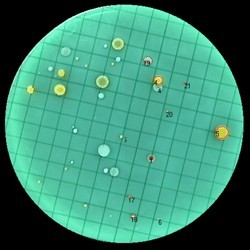

Para “High throughput” en contaje de colonias de bacterias, placas bacteriófagas y células en menos de 1 sg. Diferenciación por color, tamaño y forma.
Procesa hasta 400 placas por hora con hasta 1000 cuentas por placa.
SOLICITE OFERTA
Información del producto
Contador automatico de colonias “COLONYQUANT”
Para “High throughput” en contaje de colonias de bacterias, placas bacteriófagas y células en menos de 1 sg. Diferenciación por color, tamaño y forma.
Procesa hasta 400 placas por hora con hasta 1000 cuentas por placa.
Captura de imagen y evaluación inmediata, permite la detección simultanea de hasta 8 colores.
Con software de detección que permite seleccionar color, tamaño y forma.
Evaluación sectorial de 90º disponible. Permite la selección de colonias superpuestas.
Con un simple click del ratón puede cambiarse de evaluación de placas de agar o de discos de nutrientes a placas espirales o a análisis de la zona de inhibición.